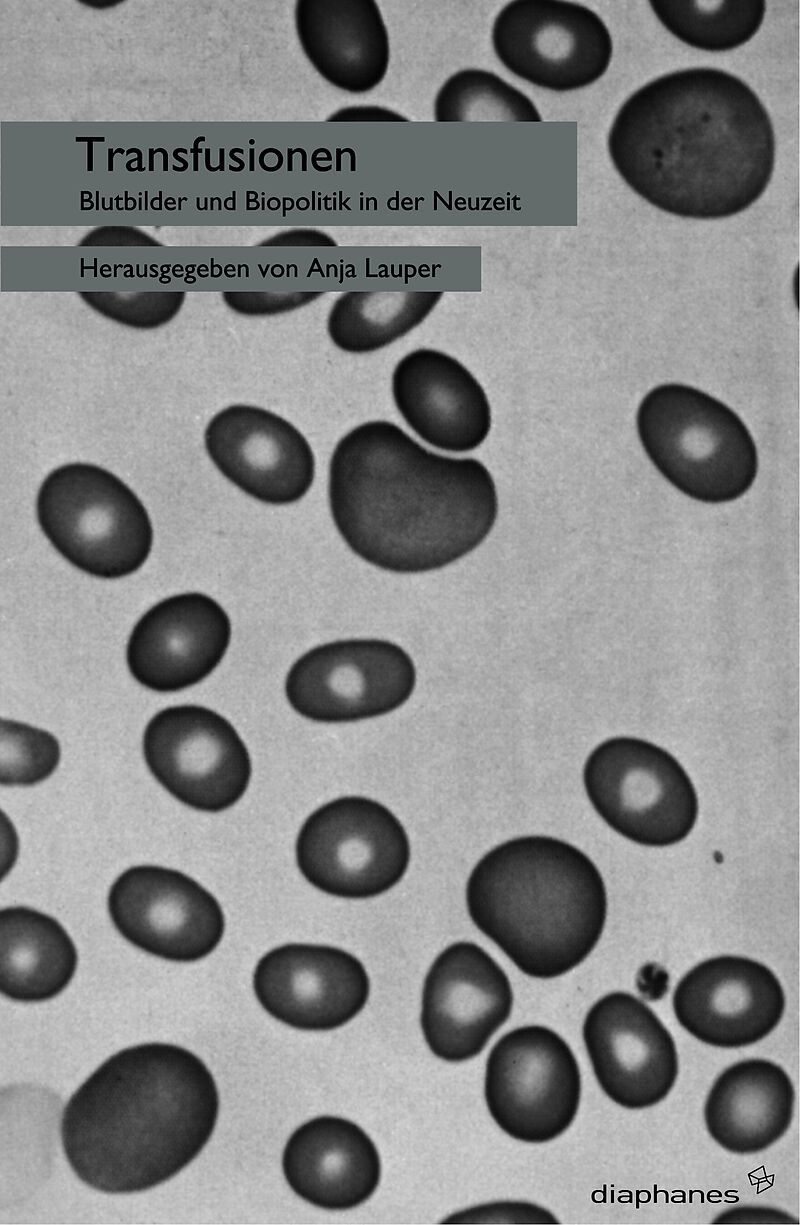

Beschreibung
Seit der frühen Neuzeit erfuhr die Rede vom Blut wiederholte Umcodierungen: transformiert sich das christliche Blut des Erlösers nach 1600 zum physiologischen Träger des Lebens, so markiert 1800 das historische Datum, an dem es vom sozialen Unterscheidungsmer...